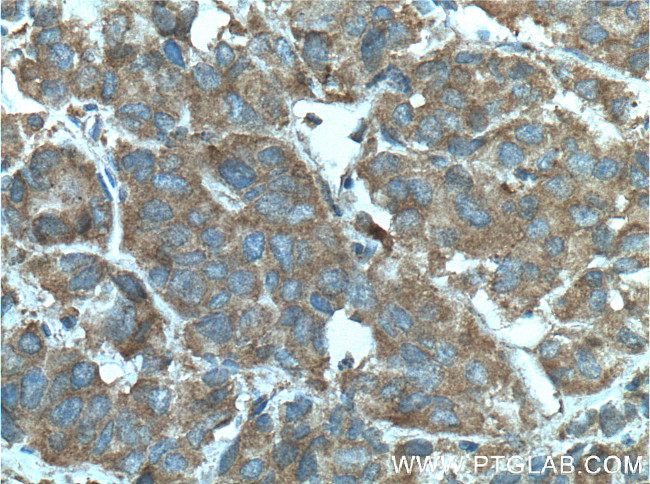
RABEP2 Antibody in Immunohistochemistry (Paraffin) (IHC (P))

Search
Proteintech
RABEP2 Monoclonal Antibody (1A4A4)
{{$productOrderCtrl.translations['antibody.pdp.commerceCard.promotion.promotions']}}
{{$productOrderCtrl.translations['antibody.pdp.commerceCard.promotion.viewpromo']}}
{{$productOrderCtrl.translations['antibody.pdp.commerceCard.promotion.promocode']}}: {{promo.promoCode}} {{promo.promoTitle}} {{promo.promoDescription}}. {{$productOrderCtrl.translations['antibody.pdp.commerceCard.promotion.learnmore']}}
产品信息
60125-1-IG
种属反应
宿主/亚型
分类
类型
克隆号
抗原
偶联物
形式
浓度
规格
纯化类型
保存液
内含物
保存条件
运输条件
产品详细信息
Immunogen sequence: MAAAAPVAA DDDERRRRPG AALEDSRSQE GANGEAESGE LSRLRAELAG ALAEMETMKA VAEVSESTKA EAVAAVQRQC QEEVASLQAI LKDSISSYEA QITALKQERQ QQQQDCEEKE RELGRLKQLL SRAYPLDSLE KQMEKAHEDS EKLREIVLPM EKEIEELKAK LLRAEELIQE IQRRPRHAPS LHGSTELLPL SRDPSPPLEP LEELSGDGGP AAEAFAHNCD DSASISSFSL GGGVGSSSSL PQSRQGLSPE QEETASLVST GTLVPEGIYL PPPGYQLVPD TQWEQLQTEM (1-299 aa encoded by BC058900)
靶标信息
RABEP2, also named as RABPT5B, plays a role in membrane trafficking and in homotypic early endosome fusion. It has two isoforms with MW 59-63 kDa.
仅用于科研。不用于诊断过程。未经明确授权不得转售。
篇参考文献 (0)
生物信息学
蛋白别名: Fos-related antigen; MP13 protein; Rab GTPase-binding effector protein 2; Rabaptin-5 beta; Rabaptin-5beta; unnamed protein product
基因别名: FRA; MP13; RABEP2; RABPT5B
UniProt ID: (Human) Q9H5N1, (Rat) Q62835
Entrez Gene ID: (Human) 79874, (Rat) 80754